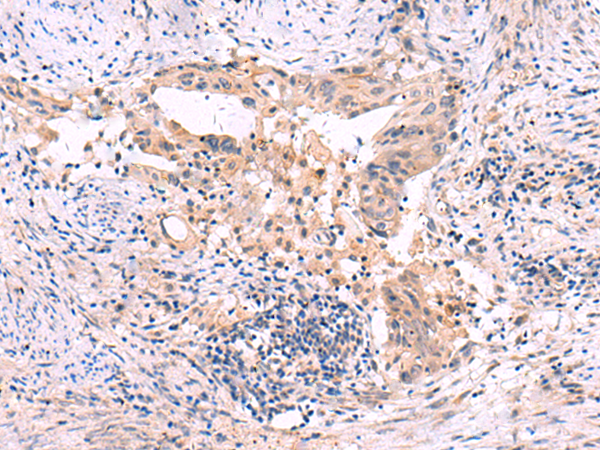

英文名稱(chēng): Anti-SLC12A5 rabbit polyclonal antibody
相關(guān)類(lèi)別: 一抗
儲(chǔ) 存: 冷凍(-20℃)
宿 主: Rabbit
抗 原: SLC12A5
反應(yīng)種屬: Human, Mouse, Rat
標(biāo)記物: Unconjugate
克隆類(lèi)型: rabbit polyclonal
技術(shù)規(guī)格
|
Background: |
K-Cl cotransporters are proteins that lower intracellular chloride concentrations below the electrochemical equilibrium potential. The protein encoded by this gene is an integral membrane K-Cl cotransporter that can function in either a net efflux or influx pathway, depending on the chemical concentration gradients of potassium and chloride. The encoded protein can act as a homomultimer, or as a heteromultimer with other K-Cl cotransporters, to maintain chloride homeostasis in neurons. Alternative splicing results in two transcript variants encoding different isoforms. |
|
Applications: |
ELISA, IHC |
|
Name of antibody: |
SLC12A5 |
|
Immunogen: |
Synthetic peptide of human SLC12A5 |
|
Full name: |
solute carrier family 12 member 5 |
|
Synonyms: |
KCC2; EIG14; hKCC2; EIEE34 |
|
SwissProt: |
Q9H2X9 |
|
ELISA Recommended dilution: |
5000-10000 |
|
IHC positive control: |
Human cervical cancer |
|
IHC Recommend dilution: |
30-150 |
購(gòu)物車(chē)
幫助
021-54845833/15800441009
